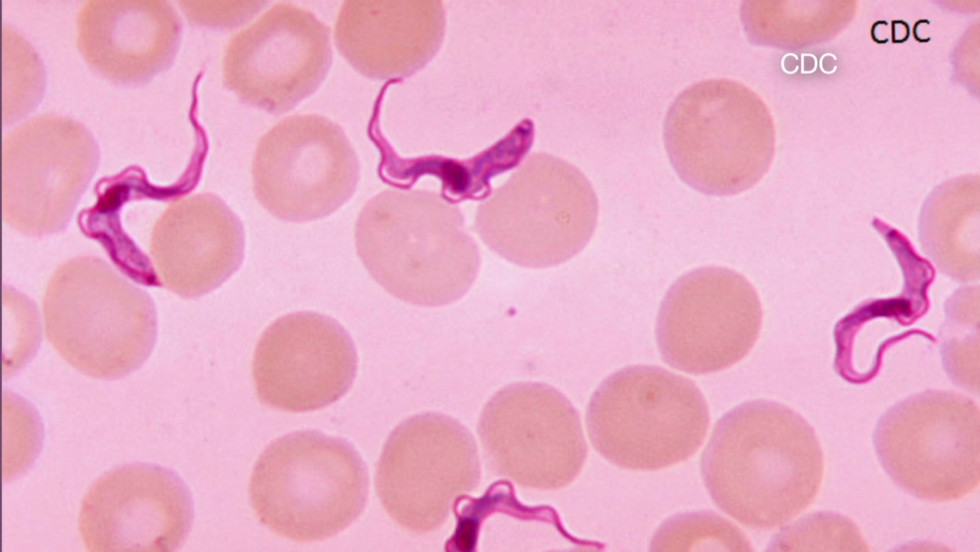

Chagas' Disease
Chagas' Disease
Microbial Diseases A to Z | Disease Home Page | Bio 406 Home Page | MicroWorld |

Chagas' Disease
Chagas' Disease Chagas' Disease is caused by the flagellated protozoan Trypanosoma cruzi. It is transmitted by reduviid bugs (kissing bugs) (vectors) from animal reservoirs (zoonosis). Unlike T. brucei, these trypanosomes have an amastigote phase that replicates inside host cells (intracellular). Key symptom is enlargement of internal organs.